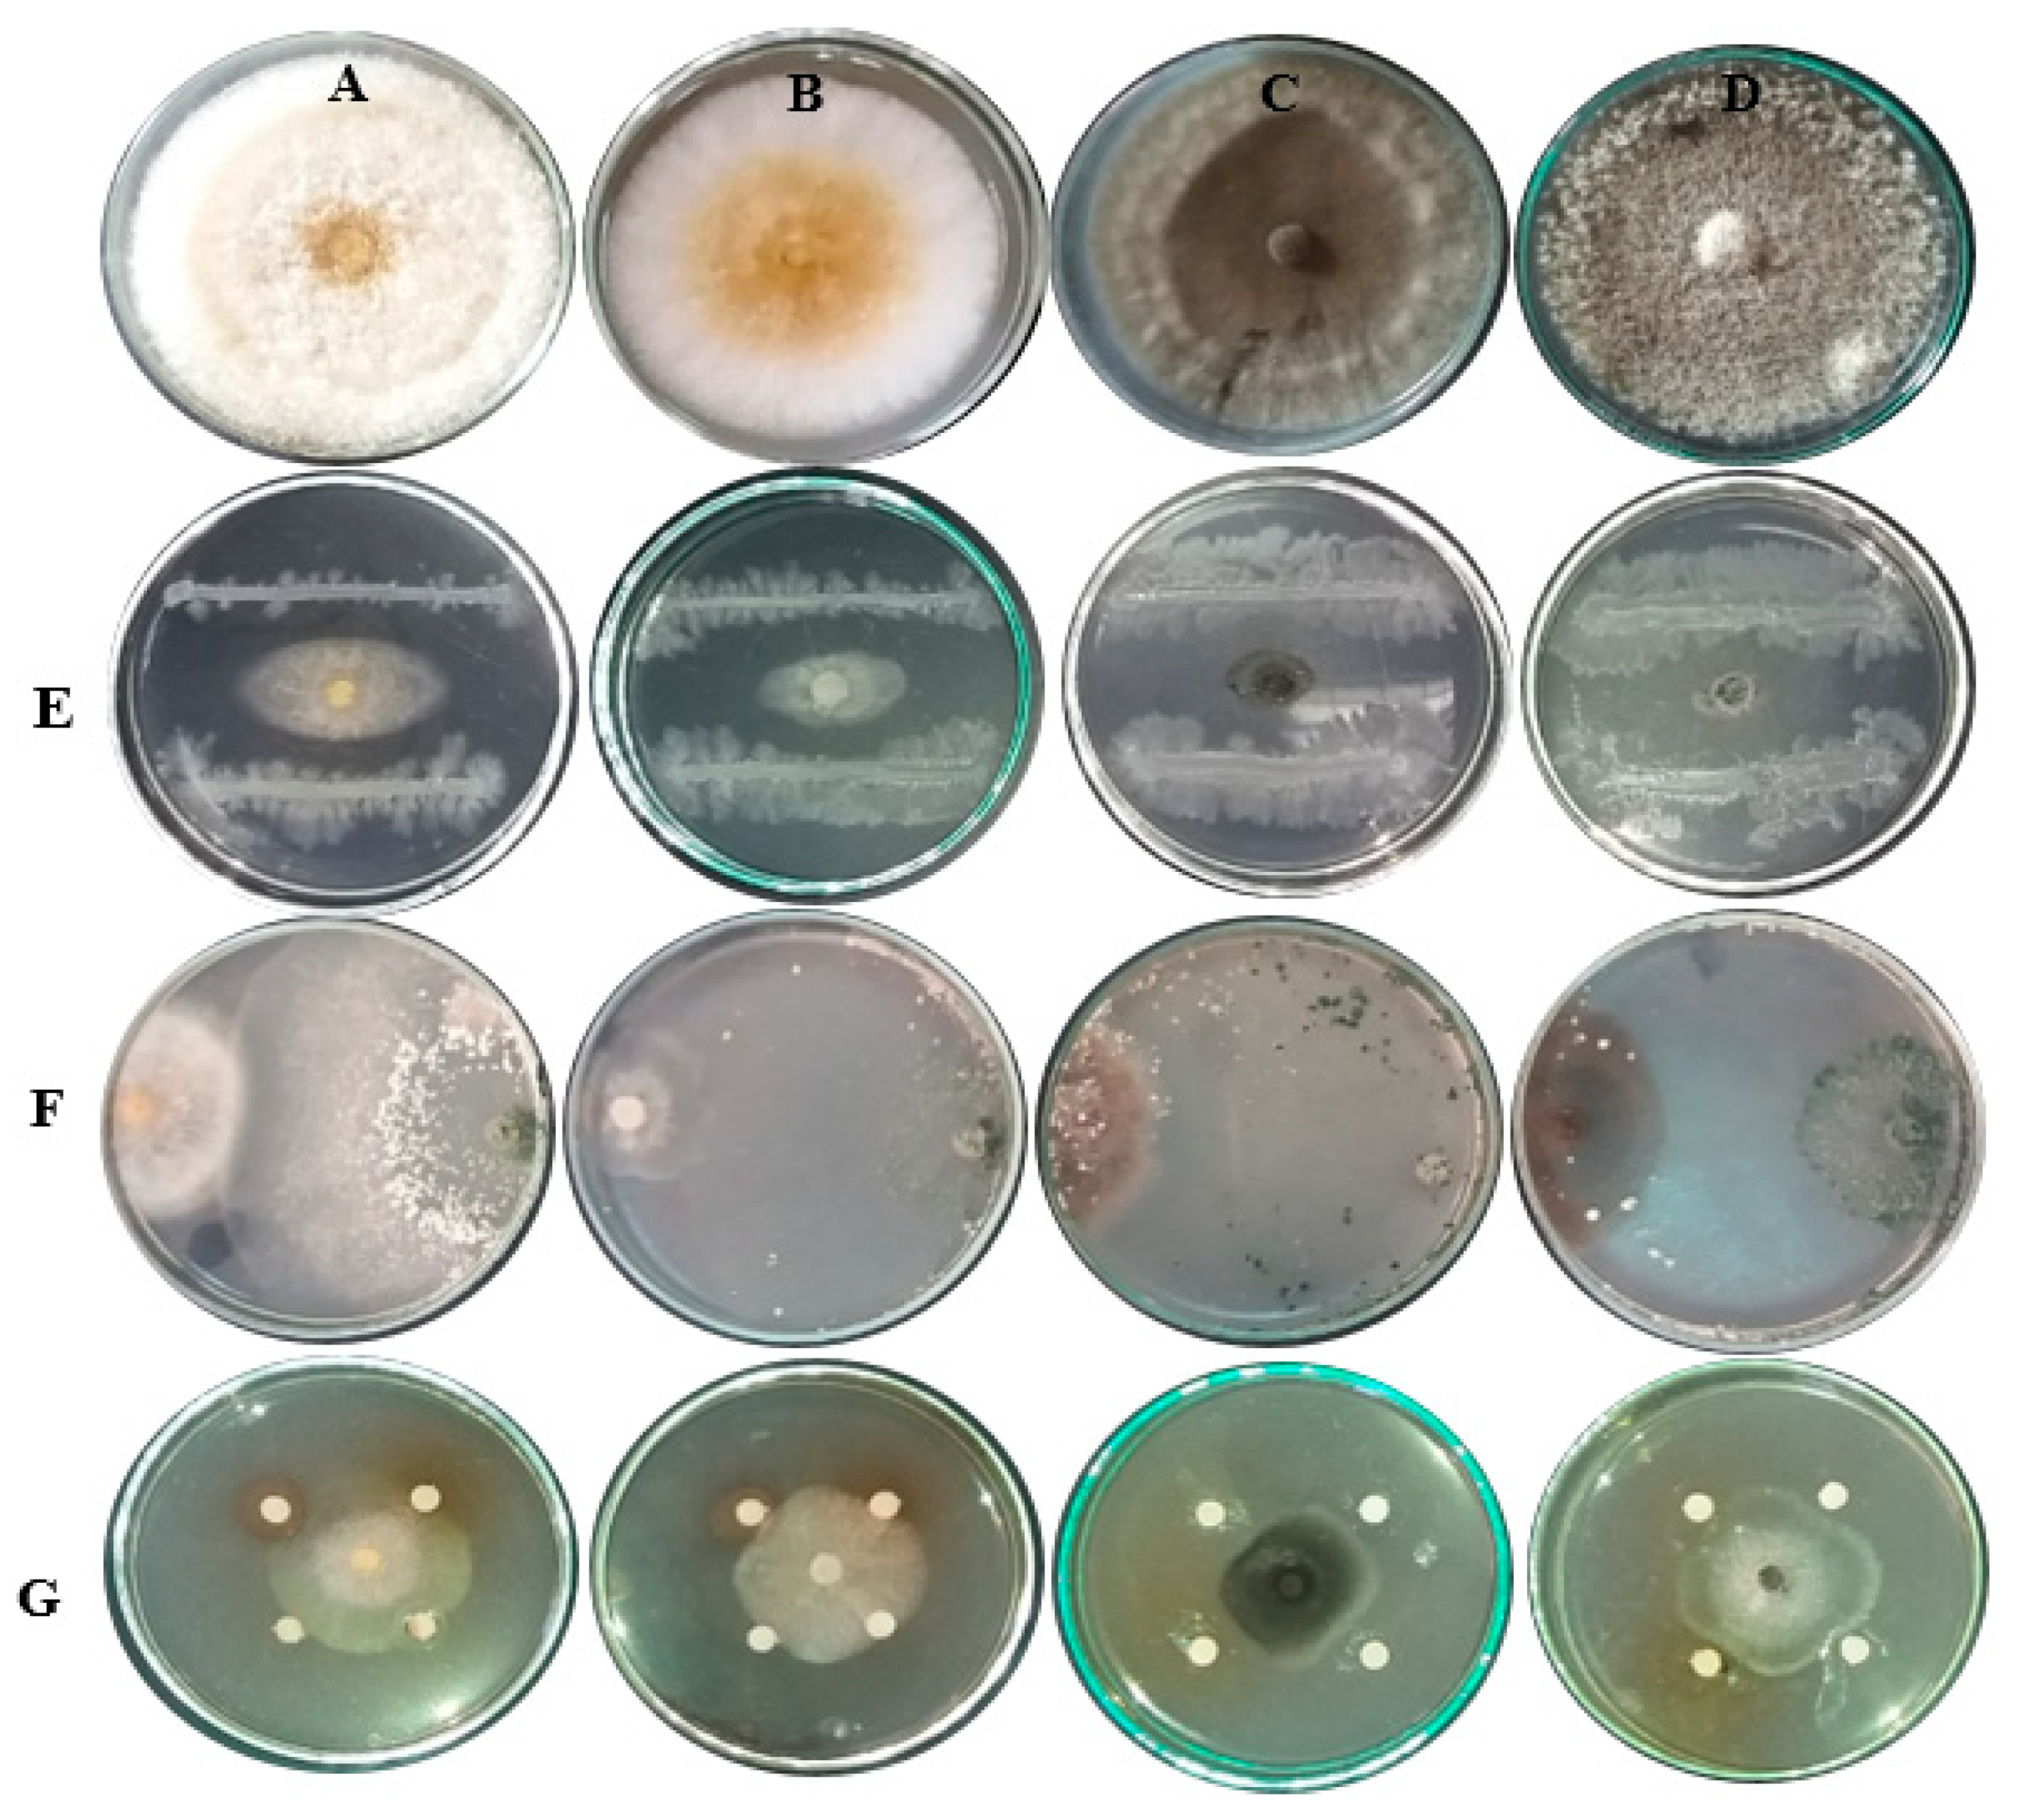
Horticulturae 07 00470 g004 Horticulturae 07 00470 g004

Natural Plant Extracts and Microbial Antagonists to Control Fungal Pathogens and Improve the Productivity of Zucchini (Cucurbita pepo L.) In Vitro and in Greenhouse
Abstract
1. Introduction
2. Materials and Methods
2.1. Isolation of the Fungal Pathogens
2.2. Morphological Identification of Fungal Isolates
2.3. Isolation and Molecular Characterization of Genomic DNA Using ITS and Sequence Analysis
2.4. Evaluation of Bioagents and Plant Extracts against Zucchini Fungal Pathogens In Vitro and In Vivo
2.4.1. Efficacy of Biological Control In Vitro
2.4.2. Preparation of Plant Extracts and Their HPLC Analysis
2.4.3. Bioactivity In Vitro
2.5. Experiments under Greenhouse Conditions
2.6. Statistical Analysis
3. Results
3.1. Isolation of the Fungal Pathogen
3.2. Morphological Characteristics of Fungal Isolates
3.3. Molecular Identification Based on rDNA-ITS Sequences
3.4. Evaluation of Bioagents and Plant Extracts against Zucchini Fungal Pathogens In Vitro
3.5. HPLC Analysis of Extracts
3.6. Characterization of Zucchini Vegetative Growth
3.7. Total Yield
4. Discussion
5. Conclusions
Author Contributions
Funding
Institutional Review Board Statement
Informed Consent Statement
Data Availability Statement
Conflicts of Interest
References
- Mahmoud, A. Occurrence of Fusarium wilt on summer squash caused by Fusarium oxysporum in Assiut, Egypt. J. Phytopathol. Pest Manag. 2016, 3, 34–45. [Google Scholar]
- Kopczyńska, K.; Kazimierczak, R.; Średnicka-Tober, D.; Barański, M.; Wyszyński, Z.; Kucińska, K.; Perzanowska, A.; Szacki, P.; Rembiałkowska, E.; Hallmann, E. The profile of selected antioxidants in two courgette varieties from organic and conventional production. Antioxidants 2020, 9, 404. [Google Scholar] [CrossRef] [PubMed]
- Piasecka-Jóźwiak, K.; Rozmierska, J.; Chabłowska, B.; Stecka, K.; Skąpska, S.; Kliszcz, M.; Szkudzińska-Rzeszowiak, E. Starter cultures for lactic acid fermentation of sweet pepper, pattypan squash and tomatoes. Pol. J. Food Nutr. Sci. 2013, 63, 95–102. [Google Scholar] [CrossRef][Green Version]
- Muntean, E.; Lazăr, V.; Muntean, N. HPLC-PDA analysis of carotenoids and chlorophylls from Cucurbita pepo L. convar Giromontiina fruits. Bul. USAMV CN 2006, 62, 94–99. [Google Scholar]
- Kręcisz, M.; Stępień, B.; Pasławska, M.; Popłoński, J.; Dulak, K. Physicochemical and quality properties of dried courgette slices: Impact of vacuum impregnation and drying methods. Molecules 2021, 26, 4597. [Google Scholar] [CrossRef]
- Verdone, M.; Rao, R.; Coppola, M.; Corrado, G. Identification of zucchini varieties in commercial food products by DNA typing. Food Control 2018, 84, 197–204. [Google Scholar] [CrossRef]
- Lust, T.A.; Paris, H.S. Italian horticultural and culinary records of summer squash (Cucurbita pepo, Cucurbitaceae) and emergence of the zucchini in 19th-century Milan. Ann. Bot. 2016, 118, 53–69. [Google Scholar] [CrossRef]
- Contreras, J.I.; Baeza, R.; Alonso, F.; Cánovas, G.; Gavilán, P.; Lozano, D. Effect of distribution uniformity and fertigation volume on the bio-productivity of the greenhouse zucchini crop. Water 2020, 12, 2183. [Google Scholar] [CrossRef]
- Sumner, D.; Dowler, C.; Johnson, A.; Glaze, N.; Phatak, S.; Chalfont, R.; Epperson, J. Rot diseases of cucumber in irrigated multiple-cropping system with pest management. Plant Dis. 1983, 67, 1071–1075. [Google Scholar] [CrossRef]
- Sumner, D.R.; Phatak, S.C.; Gay, J.D.; Chalfant, R.B.; Brunson, K.E.; Bugg, R.L. Soilborne pathogens in a vegetable double-crop with conservation tillage following winter cover crops. Crop. Prot. 1995, 14, 495–500. [Google Scholar] [CrossRef]
- Kimati, H.; Gimenes-Fernandes, N.; Soave, J.; Kurozawa, C.; Brignani Neto, F.; Bettiol, W. Guia de Fungicidas Agrícolas: Recomendações por Cultura; Grupo Paulista de Fitopatologia: Jaboticabal, Brazil, 1997; p. 225. [Google Scholar]
- Nelson, P.E.; Toussoun, T.A.; Marasas, W. Fusarium Species: An Illustrated Manual for Identification; The Pennsylvania State University Press: University Park, PA, USA, 1983; p. 193. [Google Scholar]
- Hao, Y.; Aluthmuhandiram, J.V.S.; Chethana, K.W.T.; Manawasinghe, I.S.; Li, X.; Liu, M.; Hyde, K.D.; Phillips, A.; Zhang, W. Nigrospora species associated with various hosts from Shandong Peninsula, China. Mycobiology 2020, 48, 169–183. [Google Scholar] [CrossRef]
- Khaekhum, S.; Ekprasert, J.; Suebrasri, T.; Mongkolthanaruk, W.; Riddech, N.; Jogloy, S.; Boonlue, S. The first member of Exserohilum rostratum beneficial for promoting growth and yield of sunchoke (Helianthus tuberosus L.). Rhizosphere 2021, 19, 100379. [Google Scholar] [CrossRef]
- Farag, M.F. A first record of Exserohilum rostratum as a new pathogen causing bean blight in Egypt. J. Plant. Pathol. Microbiol. 2020, 11, 496. [Google Scholar] [CrossRef]
- El Hassni, M.; El Hadrami, A.; Daayf, F.; Chérif, M.; Barka, E.A.; El Hadrami, I. Biological control of bayoud disease in date palm: Selection of microorganisms inhibiting the causal agent and inducing defense reactions. Environ. Exp. Bot. 2007, 59, 224–234. [Google Scholar] [CrossRef]
- Abass, M.H.; Hameed, M.A.; Ahmed, A.N. First report of Nigrospora sphaerica (Sacc.) Mason as a potential pathogen on date palm (Phoenix dactylifera L.). Can. J. Plant Pathol. 2013, 35, 75–80. [Google Scholar] [CrossRef]
- Abass, M.H.; Mohammed, N.H. Morphological, molecular and pathological study on Nigrospora oryzae and Nigrospora sphaerica, the leaf spot fungi of date palm. Basra J. Date Palm Res. 2014, 13, 26–38. [Google Scholar]
- Jamiołkowska, A. Fungi isolated from underground part of hot pepper (Capsicum annuum) plants cultivated in the field. Phytopathol. Pol。 2009, 51, 37–44. [Google Scholar]
- Wagner, A. Fungal communities colonising stems of hot pepper (Capsicum annuum). Phytopathol. Pol 2004, 33, 23–29. [Google Scholar]
- Baker, R.; Paulitz, T. Theoretical basis for microbial interactions leading to biological control of soilborne plant pathogens. In Principles and Practice of Managing Soilborne Plant Pathogens; Hall, R., Ed.; American Phytopathological Society: St. Paul, MN, USA, 1996; pp. 50–79. [Google Scholar]
- Haas, D.; Keel, C. Regulation of antibiotic production in root-colonizing Pseudomonas spp. and relevance for biological control of plant disease. Annu. Rev. Phytopathol. 2003, 41, 117–153. [Google Scholar] [CrossRef]
- Cabanãs, C.G.-L.; Schilirã, E.; Valverde-Corredor, A.; Mercado-Blanco, J. The biocontrol endophytic bacterium Pseudomonas fluorescens PICF7 induces systemic defense responses in aerial tissues upon colonization of olive roots. Front. Microbiol. 2014, 5, 427. [Google Scholar] [CrossRef]
- Mohamed, H.I.; Gomaa, E.Z. Effect of plant growth promoting Bacillus subtilis and Pseudomonas fluorescens on growth and pigment composition of radish plants (Raphanus sativus) under NaCl stress. Photosynthetica 2012, 50, 263–272. [Google Scholar] [CrossRef]
- Sivan, A.; Chet, I. Integrated control of media on growth and interactions between a range of soil borne glasshouse pathogens and antagonistic fungi. Phytopathology 1993, 10, 127–142. [Google Scholar]
- Whipps, J.M.; Lumsden, R.D. Commercial use of fungi as plant disease biological control agents: Status and prospects. Fungal Biocontrol Agents Prog. Probl. Potential 2001, 9–22. [Google Scholar] [CrossRef]
- McLean, K.; Dodd, S.; Sleight, B.; Hill, R.; Stewart, A. Comparison of the behaviour of a transformed hygromycin resistant strain of Trichoderma atroviride (M1057hygR) with the wildtype strain (M1057). N. Z. Plant Prot. 2004, 57, 72–76. [Google Scholar] [CrossRef]
- Simon, A.; Sivasithamparam, K. Interactions among Gaeumannomyces graminis var. tritici, Trichoderma koningii, and soil bacteria. Can. J. Microbiol. 1988, 34, 871–876. [Google Scholar] [CrossRef]
- Schirmböck, M.; Lorito, M.; Wang, Y.L.; Hayes, C.K.; Arisan-Atac, I.; Scala, F.; Harman, E.G.; Kubicek, C.P. Parallel formation and synergism of hydrolytic enzymes and peptaibol antibiotics, molecular mechanisms involved in the antagonistic action of Trichoderma harzianum against phytopathogenic fungi. Appl. Environ. Microbiol. 1994, 60, 4364–4370. [Google Scholar] [CrossRef] [PubMed]
- Dennis, C.; Webster, J. Antagonistic properties of species-groups of Trichoderma: III. Hyphal interaction. Trans. Br. Mycol. Soc. 1971, 57, 363–IN2. [Google Scholar] [CrossRef]
- Claydon, N.; Hanson, J.R.; Truneh, A.; Avent, A.G. Harzianolide, a butenolide metabolite from cultures of Trichoderma harzianum. Phytochemistry 1991, 30, 3802–3803. [Google Scholar] [CrossRef]
- Jamiołkowska, A. Natural compounds as elicitors of plant resistance against diseases and new biocontrol strategies. Agronomy 2020, 10, 173. [Google Scholar] [CrossRef]
- Salem, M.Z.M.; El-Hefny, M.; Ali, H.M.; Abdel-Megeed, A.; El-Settawy, A.A.; Böhm, M.; Mansour, M.M.; Salem, A.Z.M. Plants-derived bioactives: Novel utilization as antimicrobial, antioxidant and phytoreducing agents for the biosynthesis of metallic nanoparticles. Microb. Pathog. 2021, 158, 105107. [Google Scholar] [CrossRef]
- Salem, M.Z.M.; Mohamed, A.; Ali, H.; Al Farraj, D. Characterization of phytoconstituents from alcoholic extracts of four woody species and their potential uses for management of six Fusarium oxysporum isolates identified from some plant hosts. Plants 2021, 10, 1325. [Google Scholar] [CrossRef]
- Mohamed, A.A.; El-Hefny, M.; El-Shanhorey, N.A.; Ali, H.M. Foliar application of bio-stimulants enhancing the production and the toxicity of Origanum majorana essential oils against four rice seed-borne fungi. Molecules 2020, 25, 2363. [Google Scholar] [CrossRef] [PubMed]
- Mansour, M.M.A.; Abdel-Megeed, A.; Nasser, R.A.; Salem, M.Z.M. comparative evaluation of some woody tree methanolic extracts and paraloid B-72 against Phytopathogenic mold fungi Alternaria tenuissima and Fusarium culmorum. Bioresources 2015, 10, 2570–2584. [Google Scholar] [CrossRef]
- Salem, M.Z.M.; Alotaibi, S.; Abo Elgat, W.A.; Taha, A.; Fares, Y.; El-Shehawi, A.; Ghareeb, R. Antifungal activities of wood and non-wood kraft handsheets treated with Melia azedarach extract using SEM and HPLC analyses. Polymers 2021, 13, 2012. [Google Scholar] [CrossRef] [PubMed]
- Abd-Elkader, D.; Salem, M.Z.M.; Komeil, D.; Al-Huqail, A.; Ali, H.; Salah, A.; Akrami, M.; Hassan, H. Post-harvest enhancing and Botrytis cinerea control of strawberry fruits using low cost and eco-friendly natural oils. Agronomy 2021, 11, 1246. [Google Scholar] [CrossRef]
- Salem, M.Z.M.; Olivares-Pérez, J.; Salem, A. Studies on biological activities and phytochemicals composition of Hibiscus species-A review. Life Sci. J. 2014, 11, 1–8. [Google Scholar]
- Ashmawy, N.; Salem, M.Z.M.; El-Hefny, M.; El-Kareem, M.S.A.; El-Shanhorey, N.A.; Mohamed, A.A.; Salem, A.Z.M. Antibacterial activity of the bioactive compounds identified in three woody plants against some pathogenic bacteria. Microb. Pathog. 2018, 121, 331–340. [Google Scholar] [CrossRef]
- Righini, H.; Francioso, O.; Di Foggia, M.; Quintana, A.M.; Roberti, R. Assessing the potential of the Terrestrial Cyanobacterium Anabaena minutissima for controlling Botrytis cinerea on tomato fruits. Horticulturae 2021, 7, 210. [Google Scholar] [CrossRef]
- Stankovic, M.; Stefanovic, O.; Čomić, L.; Topuzović, M.; Radojević, I.; Solujić, S. Antimicrobial activity, total phenolic content and flavonoid concentrations of Teucrium species. Open Life Sci. 2012, 7, 664–671. [Google Scholar] [CrossRef]
- Mohamed, A.; Salah, M.; El-Dein, M.; El-Hefny, M.; Ali, H.; Farraj, D.; Hatamleh, A.; Salem, M.Z.M.; Ashmawy, N. Ecofriendly bioagents, Parthenocissus quinquefolia, and Plectranthus neochilus extracts to control the early blight pathogen (Alternaria solani) in tomato. Agronomy 2021, 11, 911. [Google Scholar] [CrossRef]
- Pitt, J.; Hocking, A. Fungi and Food Spoilage; Blackie Academic & Professional: New South Wales, Australia, 1997. [Google Scholar]
- Naik, M.; Prasad, Y.; Bhat, K.; Rani, G.D. Morphological, physiological, pathogenic and molecular variability among isolates of Alternaria solani from tomato. Indian Phytopathol. 2010, 63, 168–173. [Google Scholar]
- Matsushima, T. Icones Microfungorum a Matsushima Lectorum; Taylor & Francis Group: Oxfordshire, UK, 1976; p. 955. [Google Scholar] [CrossRef]
- Domsch, K.H.; Gams, W.; Anderson, T.H. Compendium of Soil Fungi; Academic Press: London, UK, 1980. [Google Scholar]
- Hafizi, R.; Salleh, B.; Latiffah, Z. Morphological and molecular characterization of Fusarium solani and F. oxysporum associated with crown disease of oil palm. Braz. J. Microbiol. 2013, 44, 959–968. [Google Scholar] [CrossRef] [PubMed]
- Meena, R.P.; Roy, S. Morphological and molecular characterization of Fusarium sp. causing wilt disease of isabgol (Plantago ovata Forsk.) and its management strategies. J. Appl. Res. Med. Aromat. Plants 2020, 16, 100244. [Google Scholar] [CrossRef]
- Choi, I.-Y.; Kim, J.-H.; Lee, W.-H.; Park, J.-H.; Shin, H.-D. First report on Fusarium wilt of zucchini caused by Fusarium oxysporum, in Korea. Mycobiology 2015, 43, 174–178. [Google Scholar] [CrossRef] [PubMed][Green Version]
- Liu, Y.J.; Whelen, S.; Hall, B.D. Phylogenetic relationships among ascomycetes: Evidence from an RNA polymerse II subunit. Mol. Biol. Evol. 1999, 16, 1799–1808. [Google Scholar] [CrossRef]
- Edel, V.; Steinberg, C.; Gautheron, N.; Recorbet, G.; Alabouvette, C. Genetic diversity of Fusarium oxysporum populations isolated from different soils in France. FEMS Microbiol. Ecol. 2001, 36, 61–71. [Google Scholar] [CrossRef]
- Mohamed, A.A.; Gomaa, F.H. Molecular characterization and biological control of some rice seed-borne fungal pathogens. J. Phytopathol. Pest Manag. 2019, 6, 40–53. [Google Scholar]
- White, T.J.; Bruns, T.; Lee, S.; Taylor, J. Amplification and direct sequencing of fungal ribosomal RNA genes for phylogenetics. In PCR Protocols: A Guide to Methods and Applications; Innis, M., Gelfand, D., Sninsky, J., White, T., Eds.; Academic Press Inc.: New York, NY, USA, 1990; p. 315. [Google Scholar]
- Mohamed, A.A.; Behiry, S.I.; Ali, H.M.; El-Hefny, M.; Salem, M.Z.; Ashmawy, N.A. Phytochemical compounds of branches from P. halepensis oily liquid extract and S. terebinthifolius essential oil and their potential antifungal activity. Processes 2020, 8, 330. [Google Scholar] [CrossRef]
- Mosa, W.F.A.; Salem, M.Z.M.; Al-Huqail, A.A.; Ali, H.M. Application of glycine, folic acid, and moringa extract as bio-stimulants for enhancing the production of ‘Flame Seedless’ grape cultivar. Bioresources 2021, 16, 3391–3410. [Google Scholar] [CrossRef]
- Balouiri, M.; Sadiki, M.; Ibnsouda, S.K. Methods for in vitro evaluating antimicrobial activity: A review. J. Pharm. Anal. 2016, 6, 71–79. [Google Scholar] [CrossRef]
- Rahman, M.A.; Begum, M.F.; Alam, M.F. Screening of Trichoderma isolates as a biological control agent against Ceratocystis paradoxa causing pineapple disease of sugarcane. Mycobiology 2009, 37, 277–285. [Google Scholar] [CrossRef]
- Elmohsen, Y.A.; Salman, S.R.; Helmy, Y.I.; El-Shinawy, M.Z.; Abou-Hadid, A.F. The effect of grafting on squash plants grown under low plastic tunnel in winter season. Egypt J. Hortic. 2021, 48, 181–192. [Google Scholar] [CrossRef]
- Fargo, W.S.; Bonjour, E.L.; Wagner, T.L. An estimation equation for squash leaf area using leaf measurements. Can. J. Plant. Sci. 1986, 66, 677–682. [Google Scholar] [CrossRef]
- SAS. User Guide: Statistics (Release 8.02); SAS Institute: Cary, NC, USA, 2001. [Google Scholar]
- Steel, R.; Torrie, J. Principles and Procedures of Statistics, 2nd ed.; McGraw-Hill: New York, NY, USA, 1980. [Google Scholar]
- Ashmawy, N.A.; Salem, M.Z.M.; El Shanhorey, N.; Al-Huqail, A.A.; Ali, H.M.; Behiry, S.I. Eco-friendly wood-biofungicidal and antibacterial activities of various Coccoloba uvifera L. leaf extracts: HPLC analysis of phenolic and flavonoid compounds. Bioresources 2020, 15, 4165–4187. [Google Scholar] [CrossRef]
- Savitha, A.; Naik, M.; Ajithkumar, K. Eco-friendly management of Alternaria Sesami incitant blight of sesame. J. Plant Dis. Sci. 2011, 6, 150–152. [Google Scholar]
- Hari, C.; Surender, S. Control of chickpea wilt (Fusarium oxysporum f sp. ciceri) using bioagents and plant extracts. Indian J. Agric. Sci. 2005, 75, 115–116. [Google Scholar]
- Joshi, S.; Gupta, K. Eco-friendly management of leaf spot of chickpea caused by Alternaria spp. Ann. Plant Prot. Sci. 2009, 17, 504–505. [Google Scholar]
- Tapwal, A.; Garg, S.; Gautam, N.; Kumar, R. In vitro antifungal potency of plant extracts against five phytopathogens. Braz. Arch. Biol. Technol. 2011, 54, 1093–1098. [Google Scholar] [CrossRef]
- Abo-Elyousr, K.A.M.; Bagy, H.M.M.K.; Hashem, M.; Alamri, S.A.M.; Mostafa, Y.S. Biological control of the tomato wilt caused by Clavibacter michiganensis subsp. michiganensis using formulated plant growth-promoting bacteria. Egypt J. Biol. Pest. Control 2019, 29, 54. [Google Scholar] [CrossRef]
- Jardin, P.D.; Verheggen, F.; Fassotte, B. Implementing plant biostimulants and biocontrol strategies in the agroecological management of cultivated ecosystems. Biotechnol. Agron. Soc. Environ. 2016, 20, 299–313. [Google Scholar] [CrossRef]
- Sánchez-Montesinos, B.; Santos, M.; Moreno-Gavíra, A.; Marín-Rodulfo, T.; Gea, F.; Diánez, F. Biological control of fungal diseases by Trichoderma aggressivum f. europaeum and its compatibility with fungicides. J. Fungi 2021, 7, 598. [Google Scholar] [CrossRef] [PubMed]
- Ellis, R.J.; Timms-Wilson, T.M.; Beringer, J.E.; Rhodes, D.; Renwick, A.; Stevenson, L.; Bailey, M.J. Ecological basis for biocontrol of damping-off disease by Pseudomonas fluorescens 54/96. J. Appl. Microbiol. 1999, 87, 454–463. [Google Scholar] [CrossRef] [PubMed]
- Wang, Z.; Zhong, T.; Chen, K.; Du, M.; Chen, G.; Chen, X.; Wang, K.; Zalán, Z.; Takács, K.; Kan, J. Antifungal activity of volatile organic compounds produced by Pseudomonas fluorescens ZX and potential biocontrol of blue mold decay on postharvest citrus. Food Control 2021, 120, 107499. [Google Scholar] [CrossRef]
- Ganeshan, G.; Kumar, A.M. Pseudomonas fluorescens, a potential bacterial antagonist to control plant diseases. J. Plant Interact. 2005, 1, 123–134. [Google Scholar] [CrossRef]
- Blakeman, J.P.; Fokkema, N.J. Potential for biological control of plant diseases on the Phylloplane. Annu. Rev. Phytopathol. 1982, 20, 167–190. [Google Scholar] [CrossRef]
- Oloo, J. Evaluation of Local Trichoderma Isolates for Their Efficiency in Biological Control of Fusarium Oxysporum F. Sp Phaseoli in Common Bean. Ph.D. Thesis, University of Nairobi, Nairobi, Kenya, 2013. [Google Scholar]
- Varo-Suárez, A.; Raya-Ortega, M.; Agustí-Brisach, C.; García-Ortiz-Civantos, C.; Fernández-Hernández, A.; Mulero-Aparicio, A.; Trapero, A. Evaluation of organic amendments from agro-industry waste for the control of verticillium wilt of olive. Plant Pathol. 2018, 67, 860–870. [Google Scholar] [CrossRef]
- Varo, A.; Raya-Ortega, M.; Trapero, A. Enhanced production of microsclerotia in recalcitrant Verticillium dahliae isolates and its use for inoculation of olive plants. J. Appl. Microbiol. 2016, 121, 473–484. [Google Scholar] [CrossRef]
- Varo, A.; Raya-Ortega, M.; Trapero, A. Selection and evaluation of micro-organisms for biocontrol of Verticillium dahliaein olive. J. Appl. Microbiol. 2016, 121, 767–777. [Google Scholar] [CrossRef]
- Montes-Osuna, N.; Mercado-Blanco, J. Verticillium wilt of olive and its control: What did we learn during the last decade? Plants 2020, 9, 735. [Google Scholar] [CrossRef]
- Fernández-González, A.J.; Cardoni, M.; Cabanás, C.G.-L.; Valverde-Corredor, A.; Villadas, P.J.; Fernández-López, M.; Mercado-Blanco, J. Linking belowground microbial network changes to different tolerance level towards Verticillium wilt of olive. Microbiome 2020, 8, 1–19. [Google Scholar] [CrossRef] [PubMed]
- Leyva-Pérez, M.D.L.O.; Jiménez-Ruiz, J.; Gómez-Lama Cabanás, C.; Valverde-Corredor, A.; Barroso, J.B.; Luque, F.; Mercado-Blanco, J. Tolerance of olive (Olea europaea) cv Frantoio to Verticillium dahliae relies on both basal and pathogen-induced differential transcriptomic responses. New Phytol. 2017, 217, 671–686. [Google Scholar] [CrossRef]
- Cabanás, C.G.-L.; Fernández-González, A.; Cardoni, M.; Valverde-Corredor, A.; López-Cepero, J.; Fernández-López, M.; Mercado-Blanco, J. The banana root Endophytome: Differences between mother plants and suckers and evaluation of selected bacteria to control Fusarium oxysporum f.sp. cubense. J. Fungi 2021, 7, 194. [Google Scholar] [CrossRef]
- Uddin, A.; Hussain, M.; Rahman, S.; Ahmad, H.; Roni, M. Effect of Trichoderma concentration on the growth and yield of tomato. Bangladesh Res. Publ. J. 2015, 11, 228–232. [Google Scholar]
- Pavithra, G.; Sandeep, B.; Yadav, S.; Choudhary, S. Role of Trichoderma viride and GA 3 in the growth of summer squash. Plant Arch. 2019, 19, 1173–1176. [Google Scholar]
- Sharma, M.; Saini, I.; Kaushik, P.; Aldawsari, M.M.; Al Balawi, T.; Alam, P. Mycorrhizal fungi and Pseudomonas fluorescens application reduces root-knot nematode (Meloidogyne javanica) infestation in eggplant. Saudi J. Biol. Sci. 2021, 28, 3685–3691. [Google Scholar] [CrossRef]
- Radjacommare, R.; Venkatesan, S.; Samiyappan, R. Biological control of phytopathogenic fungi of vanilla through lytic action of Trichoderma species and Pseudomonas fluorescens. Arch. Phytopathol. Plant Prot. 2010, 43, 1–17. [Google Scholar] [CrossRef]
- Paz, J.E.W.; Contreras, C.R.; Munguía, A.R.; Aguilar, C.N.; Inungaray, M.L.C. Phenolic content and antibacterial activity of extracts of Hamelia patens obtained by different extraction methods. Braz. J. Microbiol. 2018, 49, 656–661. [Google Scholar] [CrossRef]
- Agati, G.; Tattini, M. Multiple functional roles of flavonoids in photoprotection. New Phytol. 2010, 186, 786–793. [Google Scholar] [CrossRef]
- Samanta, A.; Das, G.; Das, S.K. Roles of flavonoids in plants. Carbon 2011, 100, 12–35. [Google Scholar]
- Agati, G.; Brunetti, C.; Di Ferdinando, M.; Ferrini, F.; Pollastri, S.; Tattini, M. Functional roles of flavonoids in photoprotection: New evidence, lessons from the past. Plant Physiol. Biochem. 2013, 72, 35–45. [Google Scholar] [CrossRef]
- Zeng, X.; Xi, Y.; Jiang, W. Protective roles of flavonoids and flavonoid-rich plant extracts against urolithiasis: A review. Crit. Rev. Food Sci. Nutr. 2018, 59, 2125–2135. [Google Scholar] [CrossRef]
- Lattanzio, V.; Lattanzio, V.M.; Cardinali, A. Role of phenolics in the resistance mechanisms of plants against fungal pathogens and insects. Adv. Res. 2006, 661, 23–67. [Google Scholar]
- Salem, M.Z.M.; Behiry, S.; El-Hefny, M. Inhibition of Fusarium culmorum, Penicillium chrysogenum and Rhizoctonia solani by n-hexane extracts of three plant species as a wood-treated oil fungicide. J. Appl. Microbiol. 2019, 126, 1683–1699. [Google Scholar] [CrossRef]
- Siramon, P.; Ohtani, Y.; Ichiura, H. Chemical composition and antifungal property of Eucalyptus camaldulensis leaf oils from Thailand. Rec. Nat. Prod. 2013, 7, 49–53. [Google Scholar]
- Gakuubi, M.M.; Maina, A.W.; Wagacha, J.M. Antifungal activity of essential oil of Eucalyptus camaldulensis Dehnh. against selected Fusarium spp. Int. J. Microbiol. 2017, 2017, 1–7. [Google Scholar] [CrossRef] [PubMed]
- Harish, S.; Saravanakumar, D.; Radjacommare, R.; Ebenezar, E.G.; Seetharaman, K. Use of plant extracts and biocontrol agents for the management of brown spot disease in rice. BioControl 2007, 53, 555–567. [Google Scholar] [CrossRef]
- Sabo, V.A.; Knezevic, P. Antimicrobial activity of Eucalyptus camaldulensis Dehn. plant extracts and essential oils: A review. Ind. Crop. Prod. 2019, 132, 413–429. [Google Scholar] [CrossRef] [PubMed]
- Tanase, C.; Bujor, O.-C.; Popa, V.I. Chapter 3—Phenolic natural compounds and their influence on physiological processes in plants. In Polyphenols in Plants, 2nd ed.; Watson, R.R., Ed.; Academic Press: Cambridge, MA, USA, 2019; pp. 45–58. [Google Scholar]
- Hassan, S.; El-Bebany, A.; Salem, M.Z.M.; Komeil, D. Productivity and post-harvest fungal resistance of hot pepper as affected by potassium silicate, clove extract foliar spray and nitrogen application. Plants 2021, 10, 662. [Google Scholar] [CrossRef]
- Mosa, W.F.A.; Sas-Paszt, L.; Górnik, K.; Ali, H.M.; Salem, M.Z.M. Vegetative Growth, Yield, and Fruit Quality of Guava (Psidium guajava L.) cv. Maamoura as Affected by Some Biostimulants. Bioresources 2021, 16, 7379–7399. [Google Scholar] [CrossRef]
- Abdelkhalek, A.; Salem, M.Z.M.; Kordy, A.M.; Salem, A.Z.M.; Behiry, S.I. Antiviral, antifungal, and insecticidal activities of Eucalyptus bark extract: HPLC analysis of polyphenolic compounds. Microb. Pathog. 2020, 147, 104383. [Google Scholar] [CrossRef]
- Cadahia, E.; Conde, E.; García-Vallejo, M.C.; De Simón, B.F. Tannin composition of Eucalyptus camaldulensis, E. globulus and E. rudis. Part I. Wood. Holzforschung 1997, 51, 119–124. [Google Scholar] [CrossRef]
- Singab, A.-N.; Ayoub, N.; Al-Sayed, E.; Martiskainen, O.; Sinkkonen, J.; Pihlaja, K. Phenolic constituents of Eucalyptus camaldulensis Dehnh, with potential antioxidant and cytotoxic activities. Rec. Nat. Prod. 2011, 5, 271–280. [Google Scholar]
- Elansary, H.O.; Salem, M.Z.M.; Ashmawy, N.; Yessoufou, K.; El-Settawy, A.A. In vitro antibacterial, antifungal and antioxidant activities of Eucalyptus spp. leaf extracts related to phenolic composition. Nat. Prod. Res. 2017, 31, 2927–2930. [Google Scholar] [CrossRef]
- Bashir, U.; Tahira, J.J. Evaluation of Eucalyptus camaldulensis against Fusarium solani. Int. J. Agric. Biol. 2012, 14, 675–677. [Google Scholar]
- Raza, W.; Ghazanfar, M.U.; Iftikhar, Y.; Ahmed, K.S.; Haider, N.; Rasheed, M.H. Management of early blight of tomato through the use of plant extracts. Management 2016, 1, 1123–1133. [Google Scholar]
- Bajwa, R. Antifungal activity of allelopathic plant extracts VI: In vitro control of fungal pathogens by aqueous leaf extracts of Eucalyptus. Mycopath 2005, 1, 7–12. [Google Scholar]
- Okwu, D.E.; Awurum, A.N.; Okoronkwo, J.I. Phytochemical composition and in vitro antifungal activity screening of extracts from citrus plants against Fusarium oxysporum of okra plant (Hibiscus esculentus). Pest. Technol. 2007, 1, 145–148. [Google Scholar]
- Laghabenamrouche, S.; Madani, K. Phenolic contents and antioxidant activity of orange varieties (Citrus sinensis L. and Citrus aurantium L.) cultivated in Algeria: Peels and leaves. Ind. Crop. Prod. 2013, 50, 723–730. [Google Scholar] [CrossRef]
- Sawalha, S.M.; Arraez-Roman, D.; Segura-Carretero, A.; Fernández-Gutiérrez, A. Quantification of main phenolic compounds in sweet and bitter orange peel using CE–MS/MS. Food Chem. 2009, 116, 567–574. [Google Scholar] [CrossRef]
- Manthey, J.A.; Grohmann, K. Phenols in citrus peel byproducts. Concentrations of Hydroxycinnamates and Polymethoxylated flavones in citrus peel molasses. J. Agric. Food Chem. 2001, 49, 3268–3273. [Google Scholar] [CrossRef] [PubMed]
- Favela-Hernández, J.M.J.; González-Santiago, O.; Ramírez-Cabrera, M.A.; Esquivel-Ferriño, P.C.; Camacho-Corona, M.D.R. Chemistry and pharmacology of Citrus sinensis. Molecules 2016, 21, 247. [Google Scholar] [CrossRef]
- Gattuso, G.; Barreca, D.; Gargiulli, C.; Leuzzi, U.; Caristi, C. Flavonoid composition of citrus juices. Molecules 2007, 12, 1641–1673. [Google Scholar] [CrossRef] [PubMed]
- Kalidhar, S.; Rani, G.; Yadav, L. Chemical examination of Citrus sinensis flavedo variety pineapple. Indian J. Pharm. Sci. 2009, 71, 677–679. [Google Scholar] [CrossRef]
- Saleem, M.; Farooq, A.; Ahmad, S.; Shafiq, N.; Riaz, N.; Jabbar, A.; Arshad, M.; Malik, A. Chemical constituents of Citrus sinensis var. Shukri from Pakistan. J. Asian Nat. Prod. Res. 2010, 12, 702–706. [Google Scholar] [CrossRef]
- Gopukumar, S.; Alexander, P.; Jainamboo, M.; Praseetha, P. Phytochemical screening and FT-IR analysis of Ficus benghalensis fruits. Int. J. Pharmacogn. Phytochem. Res. 2016, 8, 1529–1534. [Google Scholar]
- Mousa, O.; Vuorela, P.; Kiviranta, J.; Wahab, S.; Hiltunen, R. Bioactivity of certain Egyptian ficus species. J. Ethnopharmacol. 1994, 41, 71–76. [Google Scholar] [CrossRef]
- Kannabiran, K.; Gayathri, M. Antimicrobial activity of Hemidesmus indicus, Ficus bengalensis and Pterocarpus marsupium roxb. Indian J. Pharm. Sci. 2009, 71, 578–581. [Google Scholar] [CrossRef]
- Rao, K.B.; Ojha, V.; Preeti; Kumar, G.; Karthik, L. Phytochemical composition and antioxidant activity of Ficus benghalensis (Moraceae) leaf extract. J. Biol. Act. Prod. Nat. 2014, 4, 236–248. [Google Scholar] [CrossRef]
- Afzal, T.; Ali, Q.; Malik, A. Phenolic compounds proliferation by HPLC: To find out antibacterial activities in Ficus benghalensis plant extract. Int. J. Bot. Stud. 2020, 5, 140–144. [Google Scholar]
- Behiry, S.I.; Okla, M.K.; Alamri, S.; El-Hefny, M.; Salem, M.Z.M.; Alaraidh, I.A.; Ali, H.M.; Al-Ghtani, S.M.; Monroy, J.C.; Salem, A.Z.M. Antifungal and antibacterial activities of wood treated with Musa paradisiaca L. peel extract: HPLC analysis of Phenolic and Flavonoid contents. Processes 2019, 7, 215. [Google Scholar] [CrossRef]
- Huang, J.; Chung, W. Management of vegetable crop diseases with plant extracts. Adv. Plant Dis. Manag. 2003, 37, 153–163. [Google Scholar]
- Albuquerque, B.R.; Heleno, S.A.; Oliveira, M.B.P.P.; Barros, L.; Ferreira, I.C.F.R. Phenolic compounds: Current industrial applications, limitations and future challenges. Food Funct. 2021, 12, 14–29. [Google Scholar] [CrossRef]
- Caleja, C.; Ribeiro, A.; Barreiro, M.F.; Ferreira, I.C. Phenolic compounds as nutraceuticals or functional food ingredients. Curr. Pharm. Des. 2017, 23, 2787–2806. [Google Scholar] [CrossRef] [PubMed]
- Durazzo, A.; Lucarini, M.; Souto, E.B.; Cicala, C.; Caiazzo, E.; Izzo, A.A.; Novellino, E.; Santini, A. Polyphenols: A concise overview on the chemistry, occurrence, and human health. Phytother. Res. 2019, 33, 2221–2243. [Google Scholar] [CrossRef]
- Carocho, M.; Morales, P.; Ferreira, I.C.F.R. Natural food additives: Quo vadis? Trends Food Sci. Technol. 2015, 45, 284–295. [Google Scholar] [CrossRef]
- Soto, M.L.; Falqué, E.; Domínguez, H. Relevance of natural phenolics from grape and derivative products in the formulation of cosmetics. Cosmetics 2015, 2, 259–276. [Google Scholar] [CrossRef]
- Taofiq, O.; Heleno, S.A.; Calhelha, R.C.; Fernandes, I.P.; Alves, M.J.; Barros, L.; González-Paramás, A.M.; Ferreira, I.C.; Barreiro, M.F. Phenolic acids, cinnamic acid, and ergosterol as cosmeceutical ingredients: Stabilization by microencapsulation to ensure sustained bioactivity. Microchem. J. 2019, 147, 469–477. [Google Scholar] [CrossRef]
- Jia, Y.; Liu, B.; Cheng, D.; Li, J.; Huang, F.; Lu, Y. Dyeing characteristics and function ability of tussah silk fabric with oak bark extract. Text. Res. J. 2017, 87, 1806–1817. [Google Scholar] [CrossRef]
- Zeng, P.; Chen, X.; Qin, Y.-R.; Zhang, Y.-H.; Wang, X.-P.; Wang, J.-Y.; Ning, Z.-X.; Ruan, Q.-J.; Zhang, Y.-S. Preparation and characterization of a novel colorimetric indicator film based on gelatin/polyvinyl alcohol incorporating mulberry anthocyanin extracts for monitoring fish freshness. Food Res. Int. 2019, 126, 108604. [Google Scholar] [CrossRef]
- Domínguez-Avila, J.A.; Wall-Medrano, A.; Rodríguez, G.V.; Chen, C.-Y.O.; Salazar-López, N.J.; Robles-Sánchez, M.; González-Aguilar, G.A. Gastrointestinal interactions, absorption, splanchnic metabolism and pharmacokinetics of orally ingested phenolic compounds. Food Funct. 2017, 8, 15–38. [Google Scholar] [CrossRef] [PubMed]
- Ho, S.; Thoo, Y.Y.; Young, D.J.; Siow, L.F. Inclusion complexation of catechin by β-cyclodextrins: Characterization and storage stability. LWT 2017, 86, 555–565. [Google Scholar] [CrossRef]
- Çam, M.; Içyer, N.C.; Erdoğan, F. Pomegranate peel phenolics: Microencapsulation, storage stability and potential ingredient for functional food development. LWT 2014, 55, 117–123. [Google Scholar] [CrossRef]
- Moser, P.; Telis, V.R.N.; Neves, N.D.A.; García-Romero, E.; Gómez-Alonso, S.; Hermosín-Gutiérrez, I. Storage stability of phenolic compounds in powdered BRS Violeta grape juice microencapsulated with protein and maltodextrin blends. Food Chem. 2017, 214, 308–318. [Google Scholar] [CrossRef] [PubMed]
- Santos, A.G.; Da Rocha, G.O.; De Andrade, J.B. Occurrence of the potent mutagens 2-nitrobenzanthrone and 3-nitrobenzanthrone in fine airborne particles. Sci. Rep. 2019, 9, 1–13. [Google Scholar] [CrossRef] [PubMed]

| Treatment | Concentration |
|---|---|
| Control | Without any biological agents |
| Eucalyptus camaldulensis LE | 4000 mg/L |
| Citrus sinensis LE | 4000 mg/L |
| Ficus benghalensis FE | 4000 mg/L |
| Trichoderma viride (accession number MW647090) | 106 spore/mL |
| Pseudomonas fluorescens (accession number MW647093) | 108 CFU/mL |
| T. viride + P. fluorescens | 106 spore/mL + 108 CFU/mL |
| Treatment | Conc. | F. oxysporum | F. solani | E. rostratum | N. lacticolonia |
|---|---|---|---|---|---|
| Control | 0.00 H | 0.00 G | 0.00 I | 0.00 K | |
| E. camaldulensis LE | 4000 mg/L | 77.80 C | 78.53 ± 1.27 BC | 78.53 ± 1.27 C | 74.83 ± 1.32 C |
| 2000 mg/L | 74.83 ± 1.32 D | 76.33 ± 1.27 CD | 75.93 ± 1.72 D | 72.56 ± 1.27 C | |
| 1000 mg/L | 68.90 ± 2.20 E | 73.66 ± 0.63 DE | 73.66± 0.63 E | 69.26 ± 0.63 D | |
| 500 mg/L | 66.70 F | 71.10 E | 71.10 ± 1.10 G | 66.70 ± 1.10 EF | |
| C. sinensis LE | 4000 mg/L | 72.93 ± 0.63 D | 71.10 E | 77.80 C | 68.90 ± 2.20 DE |
| 2000 mg/L | 70.00 ± 1.10 E | 71.50 ± 4.50 E | 74.06 ± 1.32 E | 62.93 ± 1.27 G | |
| 1000 mg/L | 66.70 ± 1.10 F | 67.43 ± 0.63 F | 70.36 ± 1.27 G | 60.36 ± 0.63 HI | |
| 500 mg/L | 65.20 ± 0.69 F | 65.56 ± 1.15 F | 68.53 ± 0.63 H | 59.63 ± 4.16 I | |
| Ficus benghalensis FE | 4000 mg/L | 68.90 ± 2.20 E | 80.00 ± 2.20 B | 81.46 ± 1.27 B | 66.33 ± 0.63 F |
| 2000 mg/L | 65.96 ± 0.63 F | 74.83 ± 1.32 D | 77.43 ± 2.28 CD | 62.56 ± 0.63 GH | |
| 1000 mg/L | 62.56± 1.68 G | 71.46 ± 2.28 E | 72.93± 0.63 EF | 59.26 ± 1.27 I | |
| 500 mg/L | 61.10 ± 1.10 G | 71.46 ± 2.28 E | 71.46 ± 0.63 FG | 55.60 J | |
| P. fluorescens | 108 CFU/mL | 94.80 ± 0.69 A * | 92.20 ± 1.10 A | 96.70 A | 97.80 A |
| T. viride | 106 spore/mL | 80.03 ± 1.10 B | 81.10 ± 1.10 B | 68.16 ± 0.63 H | 78.90 ± 1.10B |
| LSD 0.05 | 1.967 | 2.892 | 1.829 | 2.466 |
| RT (min) * | Compound | Phenolic Compounds (µg/mL) | ||
|---|---|---|---|---|
| E. camaldulensis LE | C. sinensis LE | F. benghalensis FE | ||
| 5.0 | Syringic acid | 5.12 | 8.42 | 5.22 |
| 6.2 | p-Coumaric acid | 6.33 | 5.17 | 5.14 |
| 8.0 | Caffeic acid | 7.41 | 5.23 | 4.69 |
| 8.8 | Pyrogallol | 13.63 | ND | ND |
| 10.0 | Gallic acid | 4.98 | 2.33 | 10.42 |
| 10.5 | Protocatechuic acid | ND | ND | 3.08 |
| 11.1 | Ferulic acid | 5.17 | 7.56 | ND |
| Flavonoid Compounds (µg/mL) | ||||
| 3.0 | Rutin | 5.19 | ND | 4.12 |
| 4.0 | 7-OH flavone | 12.09 | ND | ND |
| 5.3 | Naringin | 14.16 | 5.33 | 3.66 |
| 7.0 | Quercetin | 11.14 | 9.52 | 8.14 |
| 8.0 | Kaempferol | 15.03 | 6.14 | 12.06 |
| 10.0 | Hesperidin | 0.69 | 14.19 | 6.44 |
| 12.01 | Catechin | ND | 4.06 | ND |
| Treatment | Experiment 1 | Experiment 1 | ||
|---|---|---|---|---|
| No. of Fruits Per Plant | Yield Per Plant (Kg) | No. of Fruits Per Plant | Yield Per Plant (Kg) | |
| Control | 16.5 ± 1.23 D * | 0.964 ± 0.24 E | 17.3 ± 1.87 E | 0.978 ± 0.26 E |
| E. camaldulensis LE | 27.8 ± 2.76 A | 1.830 ± 0.22 A | 28.6 ± 2.43 A | 1.787 ± 0.26 A |
| C. sinensis LE | 20.3 ± 1.17 C | 1.323 ± 0.22 C | 21.2 ± 1.16 C | 1.293 ± 0.21 C |
| F. benghalensis FL | 19.9 ± 1.23 C | 1.184 ± 0.24 D | 19.3 ± 1.76 D | 1.197 ± 0.12 D |
| P. fluorescens | 24.3 ± 2.21 B | 1.590 ± 0.53 B | 25.2 ± 2.21 B | 1.476 ± 0.23 B |
| T. viride | 25.7 ± 2.23 B | 1.950 ± 0.52 A | 26.4 ± 2.24 AB | 1.847 ± 0.36 A |
| P. fluorescens ± T. viride | 25.1 ± 2.45 B | 1.723 ± 0.42 AB | 25.9 ± 2.12 B | 1.656 ± 0.23 B |
| Treatments | Experiment 2 | Experiment 1 | ||
|---|---|---|---|---|
| Non-Marketable Yield (Kg·m−2) | Marketable Yield (Kg·m−2) | Non-Marketable Yield (Kg·m−2) | Marketable Yield (Kg·m−2) | |
| Control | 0.85 ± 0.05 A | 2.42 ± 0.03 D | 0.77 ± 0.01 A | 2.44 ± 0.02 D * |
| E. camaldulensis LE | 0.45 ± 0.01 D | 5.53 ± 0.12 A | 0.25 ± 0.01 D | 5.84 ± 0.05 A |
| C. sinensis LE | 0.62 ± 0.01 C | 3.70 ± 0.21 C | 0.50 ± 0.01 C | 3.90 ± 0.11 B |
| F. benghalensis FE | 0.78 ± 0.02 B | 3.21 ± 0.31 C | 0.64 ± 0.05 B | 3.30 ± 0.21 C |
| P. fluorescens | 0.50 ± 0.02 D | 4.41 ± 0.11 B | 0.59 ± 0.03 B | 4.73 ± 0.31 AB |
| T. viride | 0.63 ± 0.02 C | 5.55 ± 0.01 A | 0.66 ± 0.02 B | 5.83 ± 0.14 A |
| P. fluorescens + T. viride | 0.31 ± 0.01 E | 5.47 ± 0.01 A | 0.32 ± 0.01 D | 5.42 ± 0.15 A |
Publisher’s Note: MDPI stays neutral with regard to jurisdictional claims in published maps and institutional affiliations. |
© 2021 by the authors. Licensee MDPI, Basel, Switzerland. This article is an open access article distributed under the terms and conditions of the Creative Commons Attribution (CC BY) license (https://creativecommons.org/licenses/by/4.0/).
Share and Cite
Hassan, H.S.; Mohamed, A.A.; Feleafel, M.N.; Salem, M.Z.M.; Ali, H.M.; Akrami, M.; Abd-Elkader, D.Y. Natural Plant Extracts and Microbial Antagonists to Control Fungal Pathogens and Improve the Productivity of Zucchini (Cucurbita pepo L.) In Vitro and in Greenhouse. Horticulturae 2021, 7, 470. https://doi.org/10.3390/horticulturae7110470
Hassan HS, Mohamed AA, Feleafel MN, Salem MZM, Ali HM, Akrami M, Abd-Elkader DY. Natural Plant Extracts and Microbial Antagonists to Control Fungal Pathogens and Improve the Productivity of Zucchini (Cucurbita pepo L.) In Vitro and in Greenhouse. Horticulturae. 2021; 7(11):470. https://doi.org/10.3390/horticulturae7110470
Chicago/Turabian StyleHassan, Hanaa S., Abeer A. Mohamed, Mostafa N. Feleafel, Mohamed Z. M. Salem, Hayssam M. Ali, Mohammad Akrami, and Doaa Y. Abd-Elkader. 2021. "Natural Plant Extracts and Microbial Antagonists to Control Fungal Pathogens and Improve the Productivity of Zucchini (Cucurbita pepo L.) In Vitro and in Greenhouse" Horticulturae 7, no. 11: 470. https://doi.org/10.3390/horticulturae7110470
APA StyleHassan, H. S., Mohamed, A. A., Feleafel, M. N., Salem, M. Z. M., Ali, H. M., Akrami, M., & Abd-Elkader, D. Y. (2021). Natural Plant Extracts and Microbial Antagonists to Control Fungal Pathogens and Improve the Productivity of Zucchini (Cucurbita pepo L.) In Vitro and in Greenhouse. Horticulturae, 7(11), 470. https://doi.org/10.3390/horticulturae7110470

